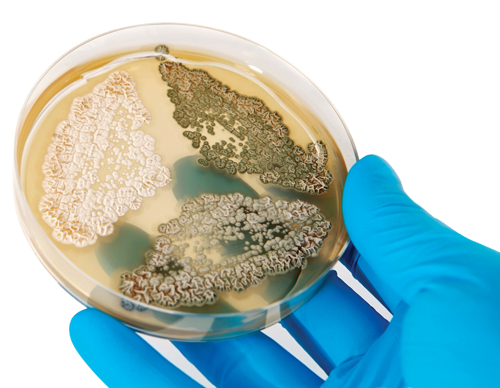

Contact Us
Need more information on Kord-Valmark's products or services? Our Sales and Customer Service Representatives are available to meet your exact needs!
Sales
sales@bioplastmfg.com
Phone: 609-807-3070
Customer Service
Toll-Free: 1.877.877.9680
Fax: (609) 245-7675